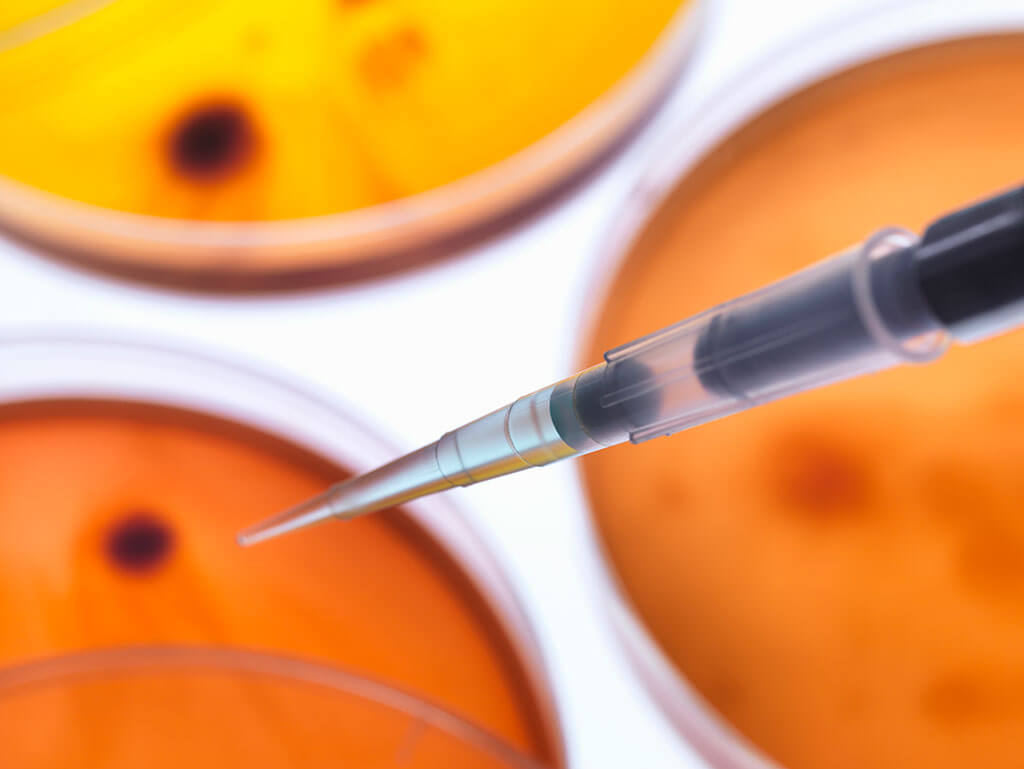
cultured bacteria in petri dish

Antimicrobial resistance (AMR) arises when microorganisms such as bacteria, viruses, fungi, and parasites develop the ability to withstand the effects of antimicrobial agents, including antibiotics, antivirals, antifungals, and antiparasitics (1). The misuse and overuse of antimicrobials in human medicine, veterinary practices and agriculture are key drivers of AMR.
AMR compromises the efficacy of modern medical practices, rendering routine surgeries, cancer therapies, and other medical procedures more hazardous. With an estimated 4.71 million deaths associated with bacterial AMR occurring globally in 2021, including 1.14 million deaths directly attributable to the same phenomenon, this global health threat is not to be underestimated. Recent projections indicate that at the current rate, over 39 million deaths could be directly attributable to bacterial AMR between 2025 and 2050 (2). Recognising the urgency for concrete action, the United Nations General Assembly adopted a political declaration in September 2024, reaffirming AMR as a global health threat and suggesting immediate measures to improve the response (3).
|
Effective treatment of bacterial infections requires innovation and investment in novel antibiotics, among other things. Despite this need, the approval rate of new antimicrobials by the United States Food and Drug Administration (U.S. FDA), for example, has significantly declined in recent years. Globally, since 2017, there have been 12 antibiotic launches, with an average revenue of US$ 5 million in the first year following the launch (4). Additionally, the number of major pharmaceutical companies actively developing new antimicrobials has drastically decreased. By December 2020,
|
only two of the top 50 pharmaceutical companies by sales were engaged in developing antimicrobials, a stark contrast to the 18 companies involved in 1990 (5). The lack of commercial success presents a significant challenge to encourage investment in antibiotic research and development (R&D), indicating that additional incentives are required to stimulate and sustain the antibiotic pipeline.
NHS innovates with a fixed fee model to stimulate research and development and ensure responsible use
To respond to this problem, the United Kingdom’s National Health Service (NHS) has proposed a new route, the Antimicrobial Products Subscription Model, as an innovative approach to incentivise the development of new antibiotics (6). Unlike traditional payment models, the subscription model provides companies with a fixed annual fee, ensuring sustainable investment in antibiotic R&D regardless of usage volume. This delinked payment structure aims to encourage the development of new antibiotics while preventing their overuse. The model is part of the UK's broader strategy to address AMR.
To qualify for the Antimicrobial Products Subscription Model, products must meet specific eligibility criteria, including targeting WHO priority pathogens and demonstrating significant clinical value to the NHS (6).